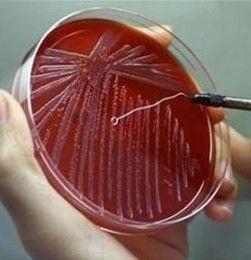
瓊脂斜面培養

操作方法
1.配製溶液
向容器內加入所需水量的一部分,按照培養基的配方,稱取各種原料,依次加入使其溶解,最後補足所需水分。對蛋白腖、肉膏等物質,需加熱溶解,加熱過程所蒸發的水分,應在全部原料溶解後加水補足。
配製固體培養基時,先將上述已配好的液體培養基煮沸,再將稱好的瓊脂加入,繼續加熱至完全融化。並不斷攪拌,以免瓊脂糊底燒焦。
2、調節pH值
用pH試紙(或pH電位計、氫離子濃度比色計)測試培養基的pH值,如不符合需要,可用10%HCl或10%NaOH進行調節,直到調節到配方要求的pH值為止。
3、過濾
用濾紙、紗布或棉花趁熱將已配好的培養基過濾。用紗布過濾時,最好摺疊成六層,用濾紙過濾時,可將濾紙摺疊成瓦棱形,鋪在漏斗上過濾。
4、分裝
已過濾的培養基應進行分裝。如果要製作斜面培養基,須將培養基分裝於試管中。如果要製作平板培養基或液體、半固體培養基,則須將培養基分裝於錐形瓶內。
分裝時,一手捏松彈簧夾,使培養基流出,另一隻手握住幾支試管或錐形瓶,依次接取培養基。分裝時,注意不要使培養基粘附管口或瓶口,以免浸濕棉塞引起雜菌污染。
裝入試管的培養基量,視試管和錐形瓶的大小及需要而定。一般製作斜面培養基時,每隻15×150毫米的試管,約裝3~4毫升(1/4~1/3試管高度),如製作深層培養基,每隻20×220毫米的試管約裝12~15毫升。每隻錐形瓶裝入的培養基,一般以其容積的一半為宜。
5、加棉塞
分裝完畢後,需要用棉塞堵住管口或瓶口。堵棉塞的主要目的是過濾空氣,避免污染。棉塞應採用普通新鮮、乾燥的棉花製作,不要用脫脂棉,以免因脫脂棉吸水使棉塞無法使用。製作棉塞時,要根據棉塞大小將棉花鋪展成適當厚度,揪取手掌心大小一塊,鋪在左手拇指與食指圈成的圓孔中,用右手食指插入棉花中部,同時左手食指與拇指稍稍緊握,就會形成1個長棒形的棉塞。棉塞作成後,應迅速塞入管口或瓶口中,棉塞應緊貼內壁不留縫隙,以防空氣中微生物沿皺摺侵入。棉塞不要過緊過松,塞好後,以手提棉塞、管、瓶不下落為合適。棉塞的2/3應在管內或瓶內,上端露出少許棉花便於拔取。塞好棉塞的試管和錐形瓶應蓋上厚紙用繩捆札,準備滅菌。
6、製作斜面培養基和平板培養基
培養基滅菌後,如製作斜面培養基和平板培養基,須趁培養基未凝固時進行。
(1)製作斜面培養基。在實驗台上放1支長0.5~1米左右的木條,厚度為1厘米左右。將試管頭部枕在木條上,使管內培養基自然傾斜,凝固後即成斜面培養基。
(2)製作平板培養基。將剛剛滅過菌的盛有培養基的錐形瓶和培養皿放在實驗台上,點燃酒精燈,右手托起錐形瓶瓶底,左手拔下棉塞,將瓶口在酒精燈上稍加灼燒,左手打開培養皿蓋,右手迅速將培養基倒入培養皿中,每皿約倒入10毫升,以鋪滿皿底為度。鋪放培養基後放置15分鐘左右,待培養基凝固後,再5個培養皿一疊,倒置過來,平放在恆溫箱裡,24小時後檢查,如培養基末長雜菌,即可用來培養微生物 。
簡捷快速製備方法
製作培養基斜面,傳統的方法是將試管每10支為一組紮成一捆,高壓滅菌後,一支一支地擺成斜面,操作比較煩瑣,占用面積又多,造成諸多不便。
1、將膠合板截成長18厘米(與試管長度相等或略短)、寬9厘米(比並排5支試管直徑的總和略窄)的小塊備用。
2、在並排5支試管上面平置截好的膠合板,再在膠合板上面並排放5支試管,然後將試管的上、下端分別用牛皮紙包好,用線紮緊,使膠合板兩側的試管保持平行,置高壓鍋中滅菌。
3、高壓滅菌後,經自然冷卻,待氣壓降至零時,將高壓鍋的鍋蓋打開點,當棉塞水分充分蒸發後取出,不用拆捆,直接擺成斜面。大量制斜面時,既快捷又很少占用空間,非常方便,還便於保溫,減緩凝結速度,充分吸收游離水分。
4、如需將斜面培養基保存一段時間,可在滅菌前將聚丙烯塑膠袋套在試管外並紮緊袋口,滅菌後取出,直接擺成斜面,可防止水分蒸發 。